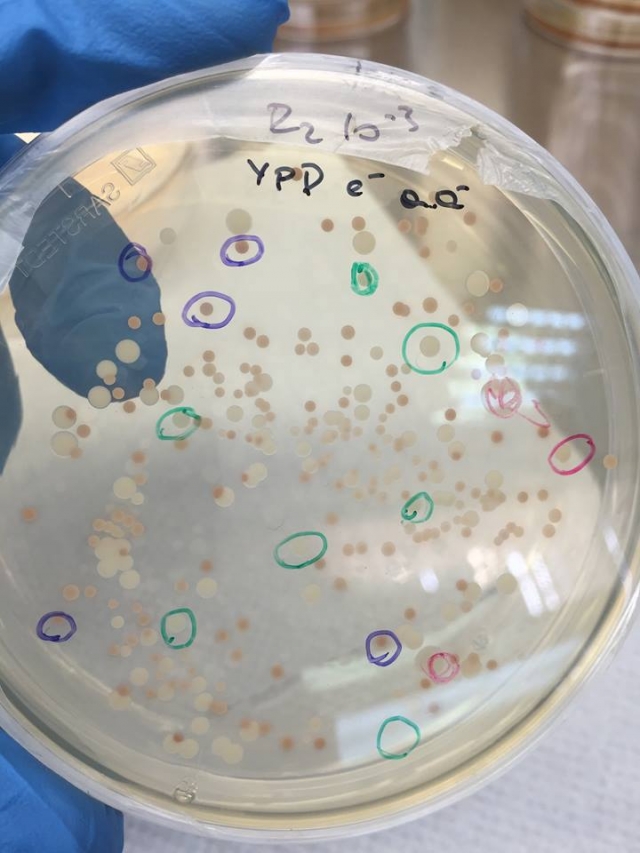

25χρονη απόφοιτος οινολόγος του ΤΕΙ Κρήτης, κατά την διάρκεια της διατριβής της στο μεταπτυχιακό τμήμα οινοποιίας ανακάλυψε κάτι πολύ πρωτοποριακό. Βρήκε τρόπο να απομονώσει ντόπιες ζύμες, από την Κρητική ποικιλία Βιδιανό, οι οποίες έιναι ικανές να αναδεικνύουν τα μοναδικά χαρακτηριστικά της ποικιλίας και χωρίς τον κίνδυνο να βλάψουν την οινοποίηση κάτι που συμβαίνει εάν αφεθεί εντελώς ελεύθερη η ζύμωση.
Σήμερα στα περισσότερα οινοποιία σκοτώνουν τις άγριες ζύμες και τις αντικαθιστούν με βελτιωμένες εμπορικές λόγω της εύκολης χρήσης τους και του εγγυημένου επαναλήψιμου αποτελέσματος που όμως κάνει τα κρασιά πανομοιότυπα.

Η νεαρή Κρητικοπούλα επιστήμονας, ονομάζεται Ηλιάνα Μαλίχιν, είναι γεωπόνος – οινολόγος και δουλεύει σε γνωστό οινοποιό του Ηρακλείου. Κατάγεται από το χωριό Λαμπινή στο Ρέθυμνο όπου είναι και πρόεδρος του πολιτιστικού συλλόγου της περιοχής . Παράλληλα καλλιεργεί το δικό της αμπελάκι, βγάζει δικό της κρασί και τις ελεύθερες ώρες της διαχειρίζεται και τις ελιές του παππού της στο Ρέθυμνο..
Αν η μοναδική της ανακάλυψη εφαρμοστεί, θα φέρει επανάσταση στο χώρο του κρασιού όχι μόνο στην Κρήτη αλλά… και στην παγκόσμια βιομηχανία, αφού θα δημιουργείται φυσικό προϊόν ανώτερης ποιότητας.
Το πρώτο βήμα της έρευνας
Η Ηλιάνα μαζί με την ομάδα της, αρχικά κατάφεραν να απομονώσουν γηγενείς ζύμες (ή αλλιώς ντόπιες) από την ποικιλία Βιδιανό, κάτι που συνέβη για πρώτη φορά στην Κρήτη.
Οι απομονώσεις έγιναν από δύο πολύ σημαντικά αμπελοτόπια για την ποικιλία. Το πρώτο βρίσκεται στον Φουρφουρά Αμαρίου στο Ρέθυμνο, όπου θεωρείται και η γενέτειρα της ποικιλίας και το δεύτερο στον Άγιο Θωμά Ηρακλείου όπου είναι η πρώτη περιοχή που φυτεύτηκε το Βιδιανό με κλήματα από τον Φουρφουρά.
Στην συνέχεια ταυτοποίησαν γενετικά τις ζύμες, έκαναν διαλογή και πραγματοποιήσαν μικρο-οινοποιήσεις (οινοποίηση σε μικρή κλίμακα) με τις ντόπιες ζύμες. Και κάλεσαν οινοπαραγωγούς, οινολόγους και γεωπόνους σε γευσιγνωσία ώστε να αξιολογήσουν και πρακτικά το κρασί.
Πως γεννήθηκε η ιδέα
Βλέποντας τις δυνατότητες της ποικιλίας «Βιδιανό» και πηγαίνοντας σε μεγάλες εκθέσεις κρασιού όπου έβλεπαν τους οινόφιλους να αναζητούν ιδιαίτερα κρασιά, πιο «φυσικά» με όσο το δυνατόν λιγότερες παρεμβάσεις και από δικές μας ελληνικές ποικιλίες διαφορετικά από τα γνωστά Chardonnay, Sauvignon blanc κτλ. γεννήθηκε η ιδέα του να ταυτοποιήσουν τις ζύμες από το Βιδιανό για το Βιδιανό.

Η ιδέα ήταν καθαρά έμπνευση της Ηλιάνας που όμως δεν θα μπορούσε να υλοποιήσει χωρίς την βοήθεια της επιστημονικής της ομάδας που αποτελούνταν από τους κ.κ. Βερβερίδη (κοσμήτορα σχολής Τεχνολογίας Γεωπονίας και Τεχνολογίας Τροφίμων του ΤΕΙ Κρήτης), Τραντά (επιβλέποντα καθηγητή της μελέτης-ΤΕΙ Κρήτης) και Γκούμα (Καθηγητή Φυτοπαθολογίας – Βακτηριολογίας-ΤΕΙ Κρήτης) καθώς και την χρηματοδότηση των ΤΕΙ Αθήνας – Σχολή Οινολογίας και Τεχνολογίας Ποτών σε συνεργασία με το ΤΕΙ Κρήτης – Σχολή Τεχνολογίας Γεωπονίας και Τεχνολογίας Τροφίμων (εκεί όπου έγινε και το πείραμα).
Η ίδια λέει για την έρευνα της στο ekriti.gr:
“Από τη μια η ανάγκη για την παραγωγή οίνων ανώτερης ποιότητας και από την άλλη η παραγωγή διαφοροποιημένων οίνων στο πλαίσιο της δημιουργίας νέων προϊόντων, έδωσαν αυτομάτως χώρο στην χρήση εναλλακτικών μεθόδων οινοποίησης. Κάτι που εγώ και η ομάδα μου, αντιληφθήκαμε από την αρχή και κυνηγήσαμε να κάνουμε πράξη.
Ευτυχώς, η προτίμηση για τους επονομαζόμενους οίνους «άγριας» * ζύμωσης προβλέπεται να αυξηθεί στο άμεσο μέλλον, αναφέρει η Ηλιάνα εξαιτίας της συνεχούς μετακίνησης των καταναλωτών από οίνους ευρείας, κατανάλωσης σε οίνους υψηλής ποιότητας καθώς και σε προϊόντα που παράγονται με φυσικές διαδικασίες και ελάχιστες τεχνολογικές παρεμβάσεις.
Έτσι, υπό το βάρος των τελευταίων εξελίξεων η αξιοποίηση στην οινοποίηση της ενδογενούς μικροχλωρίδας, ίσως το πιο σημαντικό συστατικό του τοπικού οικοσυστήματος, θα μπορούσε να προσδώσει στο προϊόν μας προστιθέμενη αξία.
Για το λόγο αυτό το ενδιαφέρον μας στράφηκε στην ανάπτυξη και τη βελτίωση της τεχνολογίας ζύμωσης με τη χρήση της ενδογενούς μικροχλωρίδας, αξιοποιώντας για πρώτη φορά στελέχη ειδών μη-Saccharomyces ή αλλιώς «άγριων» ζυμών.
Τι θέλουν να πετύχουν με αυτή την ανακάλυψη
Σε ερώτηση του ekriti τι επιδιώκουν με αυτή την σημαντική ανακάλυψη, η Ηλιάνα απαντά:
Το Βιδιανό είναι μια από τις πιο δυναμικές και ανερχόμενες κρητικές ποικιλίες καθώς μπορεί να δώσει εξαίρετο κρασί.
Από την στιγμή που χρησιμοποιούμε ξένες ζύμες αλλοιώνουμε ή τροποποιούμε το κρασί κάνοντας το αδύναμο να εκφράσει την δυναμική του τόπου όπου βρίσκεται, καθώς η Κρήτη έχει από τα πιο ιδιαίτερα terroir σε συγκριτικό πλεονέκτημα με άλλες περιοχές.
Γιατί λοιπόν να χρησιμοποιούμε τις Γαλλικές ή άλλες ξενικές ζύμες κάνοντας τα κρασιά μας πανομοιότυπα ενώ έχουμε στα χέρια μας κάτι διαφορετικό και ήδη μοναδικό;
Αυτό που θέλαμε να πετύχουμε είναι να εκτιμήσουμε για πρώτη φορά την μικροχλωρίδα της πολύ σημαντικής ποικιλίας Βιδιανό και να θέσουμε βάσεις για οινοποιήσεις με ιθαγενείς ζύμες που θα αντανακλούν τα χαρακτηριστικά γνωρίσματα τόσο της ποικιλίας όσο και του τόπου όπου καλλιεργείται , την δυναμικότητα και την τυπικότητα της ποικιλίας , με μοναδικά και διακριτά οργανοληπτικά χαρακτηριστικά, με απώτερο σκοπό την υψηλή ποιότητα του τελικού προϊόντος.

Εν τέλει το πάνελ δοκιμαστών που αξιολόγησε το κρασί ποικιλίας Βιδιανό που είχε οινοποιηθεί από αυτές τις γηγενείς ζύμες που απομονώσαμε, μίλησε για τυπικότητα και ιδιαίτερα χαρακτηριστικά, και εντυπωσίασε τους δοκιμαστές. Το κρασί χαρακτηρίστηκε ως αυθεντικό Βιδιανό!
Αυτό σημαίνει πως οφείλουμε να συνεχίσουμε την έρευνα για να επιβεβαιώσουμε την επαναληψιμότητα του αποτελέσματος μας, να δοκιμάσουμε τις ζύμες μας και σε άλλες ποικιλίες της Κρήτης, ανοίγοντας το δρόμο για την παραγωγή ποιοτικού, τυπικού, ιδιαίτερου οίνου με όσο δυνατόν λιγότερες παρεμβάσεις δημιουργώντας ένα μεγάλο πλεονέκτημα που σχετίζεται τόσο με την οικονομία αλλά και την φήμη του τόπου μας.
Τίποτα δεν θα γινόταν αν δεν αγαπούσαμε την Κρήτη και το κρητικό κρασί και δεν πιστεύαμε σε αυτόν εδώ τον τόπο. Είναι κάτι σαν όραμα. Θέλουμε να δούμε τις κρητικές ποικιλίες να παίρνουν στον κόσμο την θέση που τους αξίζει. Βεβαίως είμαστε σε καλό δρόμο γιατί το κρητικό κρασί είναι σε άνοδο αλλά και η Κρήτη διαθέτει πλέον νέα γενιά μορφωμένων οινοποιών, που έχουν ήδη αλλά και μπορούν να καταφέρουν πολλά.
Για αυτό και ζητάμε την βοήθεια του Κράτους, της Περιφέρειας, για να μπορέσουμε να συνεχίσουμε την έρευνα, η οποία άλλωστε δεν είναι έρευνα για την έρευνα. Είναι εν δυνάμει ένα εργαλείο που μπορεί να μας δώσει εμπορικό πλεονέκτημα και να συνδεθεί άμεσα με την οικονομία του τόπου μας, αλλά και την φήμη του.
Σύμφωνα με την Ηλιάνα, «ζύμες είναι οι μύκητες που ευθύνονται για την αλκοολική ζύμωση. Αυτές σε συνδυασμό με την ποικιλία μας και τον τρόπο οινοποίησης είναι που θα μας δώσουν το τελικό προφίλ του προϊόντος μας. Ανάλογα ποιες θα χρησιμοποιήσουμε θα έχουμε και διαφορετικό αποτέλεσμα.
Μπορούμε χρησιμοποιώντας 4 διαφορετικές ζύμες για την ίδια ποικιλία να πάρουμε ωστόσο 4 διαφορετικά κρασιά. Άρα οι ζύμες (φυσικά όχι και μόνο αυτές) ευθύνονται για το αν θα γίνει το κρασί μας ιδιαίτερο ή όχι. Όταν μιλάμε για άγριες ζύμες μιλάμε για μύκητες, που υπάρχουν στην φύση, δεν έχουν παραχθεί τεχνητά και είναι γένους μη-Saccharomyces. Δίνουν τα λεγόμενα κρασιά άγριας ζύμωσης ή και εμπορικά τα κρασιά τύπου «wild ferment».
πηγή : ekriti.gr
Πατριάρχου Ιωαννικείου 34, ΤΚ 73131Χανιά
Τηλ. 2821092443
Φαξ. 2821093038
e-mail: stafidiki@gmail.com